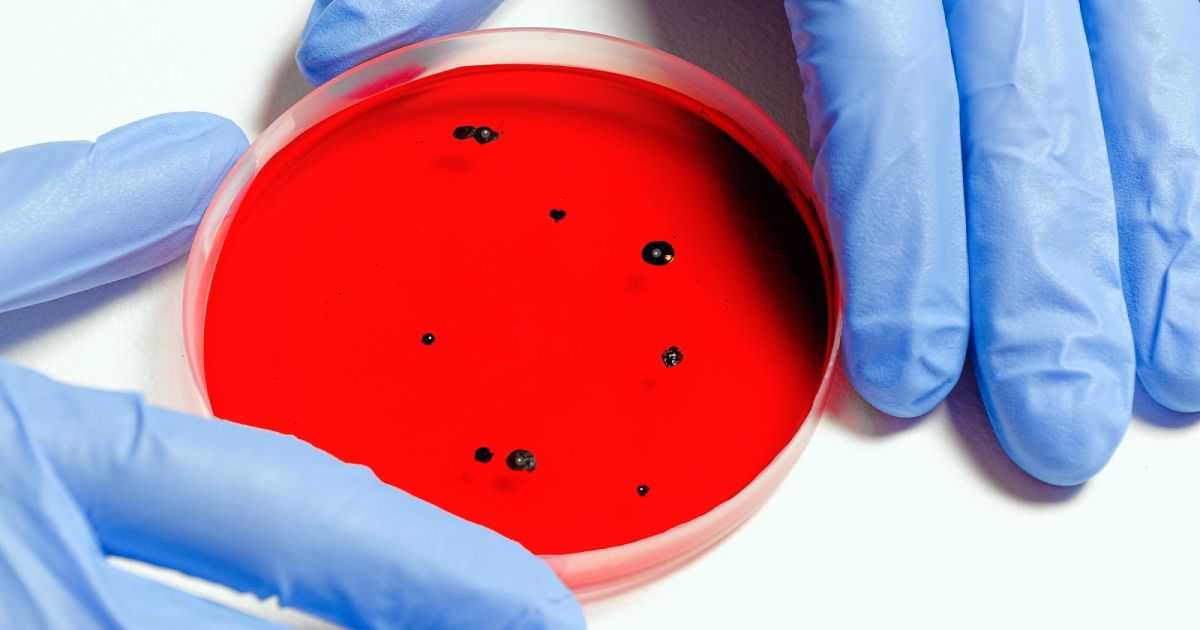
Cosmico - Personalized Medicine and Genomics

How Tech is Revolutionizing the Pharma Industry
The pharmaceutical industry plays a critical role in improving global healthcare by developing and delivering life-saving medications. In recent years, technology has been driving transformative changes within the pharma sector, revolutionizing the way drugs are discovered, developed, and distributed.
From advanced data analytics and artificial intelligence (AI) to precision medicine and telemedicine, these technological advancements are reshaping the industry landscape and bringing unprecedented benefits to patients and healthcare professionals alike.
Accelerating Drug Discovery and Development

Technology's impact on the pharmaceutical industry has brought about a profound transformation in the drug discovery and development process. Traditional drug development was known for its time-consuming and costly nature, but with the integration of artificial intelligence (AI) and data analytics, the landscape has seen remarkable improvements in efficiency and precision.
AI algorithms are now capable of analyzing vast and complex datasets, sifting through immense amounts of information to identify potential drug candidates with higher accuracy. These algorithms predict the efficacy and safety profiles of these candidates, enabling researchers to focus their efforts on the most promising compounds. As a result, the integration of AI has significantly reduced the time and resources required for preclinical and clinical trials, expediting the journey from laboratory to patient care.
Moreover, AI-powered drug discovery tools have paved the way for groundbreaking advancements, unveiling new therapeutic targets and exploring unconventional treatment pathways that were previously untapped.
This newfound approach has spurred the development of innovative medicines for conditions that were once deemed untreatable, opening doors to hope and healing for patients worldwide.
Personalized Medicine and Genomics
The field of personalized medicine has been revolutionized by remarkable advancements in genomics and molecular diagnostics. The advent of genomic sequencing and analysis has allowed researchers to delve deep into an individual's genetic makeup, uncovering critical genetic variations that can influence how they respond to drugs and their susceptibility to certain diseases.
Armed with this invaluable genetic information, healthcare professionals are now equipped to design tailor-made treatments that align precisely with a patient's unique genetic profile. This personalized approach to medicine not only maximizes treatment efficacy but also minimizes the risk of adverse reactions, enhancing patient safety and well-being.
One of the most promising areas where personalized medicine holds immense potential is in the management of cancer. With targeted therapies, healthcare providers can now identify specific genetic mutations present in a patient's tumor, enabling them to administer drugs that are precisely matched to the individual's unique genetic alterations. This targeted approach has shown remarkable success in improving treatment outcomes and has become a beacon of hope for many cancer patients.
Additionally, gene therapies have emerged as a groundbreaking innovation in personalized medicine, offering a novel way to treat genetic disorders by directly addressing the underlying genetic defects. By delivering corrective genes to patients, gene therapies hold the potential to cure or significantly alleviate the impact of genetic diseases, revolutionizing how we approach and manage such conditions.
As technology continues to evolve, the promise of personalized medicine becomes even more tangible, poised to transform the treatment landscape and bring about a new era of precise, effective, and patient-centric healthcare.
Supply Chain Optimization and Drug Traceability

The integration of technology, particularly blockchain, has brought about a transformative shift in the pharmaceutical supply chain, fostering efficiency and transparency at every stage. Blockchain technology, with its distributed and immutable ledger, plays a pivotal role in ensuring end-to-end traceability of pharmaceutical products, from the sourcing of raw materials to the eventual consumption by patients.
By incorporating blockchain into their supply chain systems, the pharmaceutical industry can effectively tackle the pressing challenge of drug counterfeiting, as every transaction and movement of drugs is securely recorded and cannot be tampered with. This authentication mechanism assures patients and healthcare professionals of the genuineness and quality of medicines, safeguarding them from the risks associated with counterfeit drugs.
In addition to combating counterfeiting, the decentralized nature of blockchain empowers pharmaceutical companies with real-time visibility into the movement of drugs, allowing for seamless tracking of shipments and inventory. This real-time monitoring capability significantly reduces the likelihood of stockouts and supply chain bottlenecks, ensuring that medicines reach patients when and where they are needed most.
Moreover, the transparency provided by blockchain technology enables pharma companies to optimize their inventory management, avoiding excessive stockpiling and minimizing waste. As a result, pharmaceutical companies can respond more effectively to unforeseen disruptions, such as supply chain disruptions caused by natural disasters or unforeseen events, ensuring a more resilient and responsive pharmaceutical supply chain.
Telemedicine and Remote Patient Monitoring

The advent of telemedicine and remote patient monitoring has brought about a revolution in healthcare delivery, particularly during the recent global health crisis. Telemedicine platforms like Teladoc and Doctor on Demand have emerged as a powerful solution, enabling patients to connect with healthcare professionals remotely through video consultations and virtual visits.
This transformation in healthcare access has significantly reduced the need for in-person visits, particularly for routine check-ups and minor medical concerns, making medical services more convenient and accessible to patients regardless of their geographical location. Telemedicine has proven to be a game-changer, especially in remote or underserved areas, where access to healthcare facilities might be limited. Patients now have the opportunity to receive expert medical advice and treatment without the need to travel long distances, improving overall healthcare outcomes and patient satisfaction.
In tandem with telemedicine, remote patient monitoring devices have gained prominence in healthcare, empowering patients to proactively manage their health and allowing healthcare providers to deliver more personalized and continuous care. Wearable health trackers, mobile health apps, and other connected devices collect real-time health data, such as heart rate, blood pressure, and glucose levels, providing valuable insights into a patient's health status.
This wealth of data enables healthcare professionals to remotely monitor patients' conditions, track health trends over time, and detect any deviations from the norm, which may indicate potential health issues. For individuals with chronic conditions, remote patient monitoring is particularly beneficial, as it allows for early detection of health complications and timely intervention, preventing exacerbation of medical conditions and reducing the need for hospitalizations. Moreover, patients are empowered to actively participate in their healthcare journey, as they gain a deeper understanding of their health metrics and can make informed decisions to improve their overall well-being.
Final Thoughts
As technology continues to evolve, it brings immense potential to the pharmaceutical industry, empowering drug development, improving patient care, and optimizing operational processes.
With AI-driven drug discovery, personalized medicine, blockchain-enabled supply chains, and telemedicine solutions, the pharma industry is poised to deliver safer, more effective, and accessible treatments to patients worldwide.
By harnessing the power of technology, the pharmaceutical sector is embracing innovation and shaping the future of healthcare for the better.